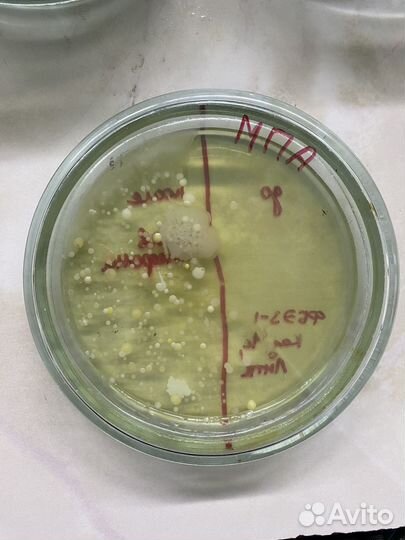
Репетитор по биологии

Репетитор по биологии
600 руб.
Первое занятие – бесплатно!
Здравствуйте! Меня зовут Алина, я студентка 4 курса биологического факультета МГАВМиБ им. К.И. Скрябина. Помогу Вам поднять успеваемость и подготовиться к ОГЭ!
Записаться на занятия можно, написав в сообщения Авито.
Объвление найдено на сайте avito.ru. Перейдите по ссылке для покупки или просмотра более подробной информации
























